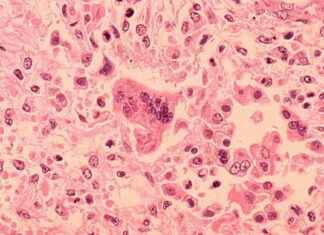
Measles Outbreak Alert: Cases in Chicago & O’Hare Airport measles-outbreak-alert-cases-in-chicago-ohare-airport

Tag: Public health alert
Cucumber Recall in Illinois: New Brands Added to List Amid Multistate Salmonella Outbreak
Alright, so there's been some drama around cucumbers lately. Apparently, there's been a salmonella outbreak tied to cucumbers from Bedner Growers, Inc. and distributed by Fresh Start Produce Sales, Inc. The FDA announced that...
FDA Recalls Cucumbers Over Multistate Salmonella Outbreak
The FDA has issued a recall of cucumbers grown by Bedner Growers, Inc., and distributed by Fresh Start Produce Sales, Inc. due to a Salmonella outbreak that has affected over 20 people. The cucumbers...
Measles Outbreak Alert: Cases in Chicago & O’Hare Airport
Two cases of measles have been reported in Cook County, and it looks like things are heating up in 2025. The Chicago Department of Public Health and Cook County Department of Public Health are...